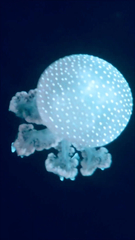
Mastigiidae

©brutledge, some rights reserved (CC-BY-NC)
©brutledge, some rights reserved (CC-BY-NC)
©Kerryn Wood, some rights reserved (CC-BY-NC)
©Kerryn Wood, some rights reserved (CC-BY-NC)
©Kerryn Wood, some rights reserved (CC-BY-NC)
©Kerryn Wood, some rights reserved (CC-BY-NC)
©ragedusmc, some rights reserved (CC-BY-NC)
©roderick88, some rights reserved (CC-BY-NC)
©roderick88, some rights reserved (CC-BY-NC)
©roderick88, some rights reserved (CC-BY-NC)
©roderick88, some rights reserved (CC-BY-NC)
©dsmshark, some rights reserved (CC-BY-NC)
©dsmshark, some rights reserved (CC-BY-NC)
©dsmshark, some rights reserved (CC-BY-NC)
©james-patrick, some rights reserved (CC-BY-NC)
©Khong Shi Mun 147524, some rights reserved (CC-BY-NC)
©Khong Shi Mun 147524, some rights reserved (CC-BY-NC)
©Ku Yan Ting 148647, some rights reserved (CC-BY-NC)
©Gillian Fitzgerald, some rights reserved (CC-BY-NC)
©Eric Crandall, some rights reserved (CC-BY)
©Anne Laudisoit, some rights reserved (CC-BY-NC)
©Anne Laudisoit, some rights reserved (CC-BY-NC)
©angelmi, some rights reserved (CC-BY-NC)
©angelmi, some rights reserved (CC-BY-NC)
©angelmi, some rights reserved (CC-BY-NC)
©angelmi, some rights reserved (CC-BY-NC)
©kilodeltalima3, some rights reserved (CC-BY-NC)
©ad-a-jiachihsu, some rights reserved (CC-BY-NC)
©andypatrick, some rights reserved (CC-BY-NC)
©maluruto72, some rights reserved (CC-BY-NC)
©Julien Lepage, some rights reserved (CC-BY)
©Hannah, some rights reserved (CC-BY-NC)
©jessicanne, some rights reserved (CC-BY-NC)
©aezium, some rights reserved (CC-BY-NC)
©bellumknight, some rights reserved (CC-BY-NC)
©bellumknight, some rights reserved (CC-BY-NC)
©Jeff Davis, some rights reserved (CC-BY-NC)
©Michal Javurek, some rights reserved (CC-BY-NC)
©juanjoseochoa, some rights reserved (CC-BY-NC)
©Shannon, some rights reserved (CC-BY-NC)
©Vince Smith, some rights reserved (CC-BY)
©bellumknight, some rights reserved (CC-BY-NC)
©bellumknight, some rights reserved (CC-BY-NC)
©bellumknight, some rights reserved (CC-BY-NC)
©bellumknight, some rights reserved (CC-BY-NC)
©bellumknight, some rights reserved (CC-BY-NC)
©bellumknight, some rights reserved (CC-BY-NC)
©Adam, some rights reserved (CC-BY-NC)
©meganton, some rights reserved (CC-BY-NC)
©Luca Li Pizzi, some rights reserved (CC-BY-NC)
©obiwantknitobi, some rights reserved (CC-BY-NC)
©claudiaa96, some rights reserved (CC-BY-NC)
©claudiaa96, some rights reserved (CC-BY-NC)
©Ana Luz, some rights reserved (CC-BY-NC)
©agl60, some rights reserved (CC-BY-NC)
©isabellaruiz619, some rights reserved (CC-BY-NC)
©krystal2713, some rights reserved (CC-BY-NC)
©hannahsdad, some rights reserved (CC-BY-NC)
©katie_roseman, some rights reserved (CC-BY-NC)
©katie_roseman, some rights reserved (CC-BY-NC)
©katie_roseman, some rights reserved (CC-BY-NC)
©katie_roseman, some rights reserved (CC-BY-NC)
©Chloe, some rights reserved (CC-BY-NC)
©coolassbugs, some rights reserved (CC-BY-NC)
©hannahsdad, some rights reserved (CC-BY-NC)
©abk19a, some rights reserved (CC-BY-NC)
©wolfd328, some rights reserved (CC-BY-NC)
©bcatsinat22, some rights reserved (CC-BY-NC)
©zoologistgrandpa, some rights reserved (CC-BY-NC)
©vmxio_, some rights reserved (CC-BY-NC)
©jhessler7, some rights reserved (CC-BY-NC)
©yolanda, some rights reserved (CC-BY-NC)